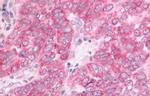
DUSP22 Antibody in Immunohistochemistry (Paraffin) (IHC (P))

Search
Invitrogen
DUSP22 Polyclonal Antibody
{{$productOrderCtrl.translations['antibody.pdp.commerceCard.promotion.promotions']}}
{{$productOrderCtrl.translations['antibody.pdp.commerceCard.promotion.viewpromo']}}
{{$productOrderCtrl.translations['antibody.pdp.commerceCard.promotion.promocode']}}: {{promo.promoCode}} {{promo.promoTitle}} {{promo.promoDescription}}. {{$productOrderCtrl.translations['antibody.pdp.commerceCard.promotion.learnmore']}}
产品信息
PA1-32648
宿主/亚型
分类
类型
抗原
偶联物
形式
浓度
规格
保存条件
运输条件
RRID
产品详细信息
PA1-32648 detects MKPX from human samples.
PA1-32648 has been successfully used in immunohistochemistry (paraffin tissue) applications.
The PA1-32648 immunogen is: Synthetic peptide, KLH conjugated.
靶标信息
Mitogen-activated protein (MAP) kinases are a large class of proteins involved in signal transduction pathways that are activated by a range of stimuli and mediate a number of physiological and pathological changes in the cell. Dual specificity phosphatases (DSPs) are a subclass of the protein tyrosine phosphatase (PTP) gene superfamily, which are selective for dephosphorylating critical phosphothreonine and phosphotyrosine residues within MAP kinases. DSP gene expression is induced by a host of growth factors and/or cellular stresses, thereby negatively regulating MAP kinase superfamily members including MAPK/ERK, SAPK/JNK and p38. DUSP22 dephosphorylates ERK2 MAP kinase and JNK. DUSP22 displays highest in thymus, but it is also detectable in monocytes and lymphocytes.
仅用于科研。不用于诊断过程。未经明确授权不得转售。